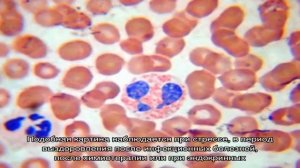

1:07
1:07
2025-02-24 12:51

 6:05
6:05

 6:05
6:05
2025-10-08 19:14

 14:17
14:17

 14:17
14:17
2025-09-20 07:46

 4:05
4:05

 4:05
4:05
2024-04-19 01:01

 3:23
3:23

 3:23
3:23
2023-12-25 04:07

 0:59
0:59

 0:59
0:59
2024-11-12 19:58

 3:20
3:20

 3:20
3:20
2024-04-15 20:29

 49:41
49:41

 49:41
49:41
2023-11-03 04:25

 2:23
2:23

 2:23
2:23
2023-12-25 21:54

 5:22
5:22

 5:22
5:22
2024-03-04 06:00

 7:02
7:02

 7:02
7:02
2025-10-08 19:14
![️ Мохито - Не Беги От Меня (LIVE @ Авторадио)]() 3:49
3:49
 3:49
3:49
2019-12-30 11:05

 6:53
6:53

 6:53
6:53
2023-05-05 15:46

 2:23
2:23

 2:23
2:23
2022-10-20 09:25

 3:38
3:38

 3:38
3:38
2022-04-09 14:15

 3:36
3:36

 3:36
3:36
2025-05-11 16:37

 10:07
10:07

 10:07
10:07
2025-09-29 11:00

 23:35
23:35
![Рейсан Магомедкеримов, Ренат Омаров - Бла-та-та (Премьера клипа 2025)]() 2:26
2:26
![Рустам Батербиев - Пора расстаться (Премьера клипа 2025)]() 2:38
2:38
![Любовь Попова - Прощай (Премьера клипа 2025)]() 3:44
3:44
![Азимжон Сайфуллаев - Тупрок буламиз (Премьера клипа 2025)]() 4:38
4:38
![TASSO - Таю (Премьера клипа 2025)]() 3:23
3:23
![Олег Семенов - Бархатный сезон (Премьера клипа 2025)]() 3:51
3:51
![MARSO - Дура (Премьера клипа 2025)]() 3:05
3:05
![Ольга Бузова - Не надо (Премьера клипа 2025)]() 3:15
3:15
![ARTEE - Лети (Премьера клипа 2025)]() 3:13
3:13
![Ганишер Раззоков - Дилижон (Премьера клипа 2025)]() 3:46
3:46
![5sta Family - Антидот (Премьера клипа 2025)]() 3:33
3:33
![Сергей Сухачёв - Розовый туман (Премьера клипа 2025)]() 3:13
3:13
![Женя Белоусова - Кто тебе сказал (Премьера клипа 2025)]() 3:27
3:27
![Динара Швец - Новая история (Премьера клипа 2025)]() 3:45
3:45
![MILEN - Украду тебя (Премьера 2025)]() 3:40
3:40
![Джатдай - Забери печаль (Премьера клипа 2025)]() 2:29
2:29
![Алмас Багратиони - Сила веры (Премьера клипа 2025)]() 3:18
3:18
![Артур Пирожков - ALARM (Премьера клипа 2025)]() 3:22
3:22
![INSTASAMKA - BOSS (Премьера клипа 2025)]() 3:41
3:41
![Ольга Сокурова, Ислам и Карина Киш – СИ ГУГЪАПlЭ (Премьера клипа 2025)]() 3:20
3:20
![Хани, не надо! | Honey Don't! (2025)]() 1:29:32
1:29:32
![Плохой Cанта 2 | Bad Santa 2 (2016) (Гоблин)]() 1:28:32
1:28:32
![Диспетчер | Relay (2025)]() 1:51:56
1:51:56
![Одноклассницы | St. Trinian's (2007)]() 1:36:32
1:36:32
![Непрощённая | The Unforgivable (2021)]() 1:54:10
1:54:10
![Сверху вниз | Highest 2 Lowest (2025)]() 2:13:21
2:13:21
![Вечеринка только начинается | The Party's Just Beginning (2018)]() 1:31:20
1:31:20
![Порочный круг | Vicious (2025)]() 1:42:30
1:42:30
![Элис, дорогая | Alice, Darling (2022)]() 1:29:30
1:29:30
![Любимец женщин | Roger Dodger (2002)]() 1:41:29
1:41:29
![Супруги Роуз | The Roses (2025)]() 1:45:29
1:45:29
![Лучшее Рождество! | Nativity! (2009)]() 1:46:00
1:46:00
![Большое смелое красивое путешествие | A Big Bold Beautiful Journey (2025)]() 1:49:20
1:49:20
![Когда ты закончишь спасать мир | When You Finish Saving the World (2022)]() 1:27:40
1:27:40
![Мужчина у меня в подвале | The Man in My Basement (2025)]() 1:54:48
1:54:48
![Никто 2 | Nobody 2 (2025)]() 1:29:27
1:29:27
![Фантастическая четвёрка: Первые шаги | The Fantastic Four: First Steps (2025)]() 1:54:40
1:54:40
![Сумерки | Twilight (2008)]() 2:01:55
2:01:55
![Стив | Steve (2025)]() 1:33:34
1:33:34
![Дикари | The Savages (2007)]() 1:54:19
1:54:19
![Отважные мишки]() 13:00
13:00
![Панда и петушок Лука]() 12:12
12:12
![Простоквашино. Финансовая грамотность]() 3:27
3:27
![Корги по имени Моко. Домашние животные]() 1:13
1:13
![Пингвиненок Пороро]() 7:42
7:42
![Врумиз. 1 сезон]() 13:10
13:10
![Котёнок Шмяк]() 11:04
11:04
![Лудлвилль]() 7:09
7:09
![Истории Баданаму Сезон 1]() 10:02
10:02
![Сборники «Зебра в клеточку»]() 45:30
45:30
![Отряд А. Игрушки-спасатели]() 13:06
13:06
![Агент 203]() 21:08
21:08
![Зебра в клеточку]() 6:30
6:30
![Последний книжный магазин]() 11:20
11:20
![Поймай Тинипин! Королевство эмоций]() 12:24
12:24
![Сборники «Простоквашино»]() 1:04:60
1:04:60
![Сборники «Оранжевая корова»]() 1:05:15
1:05:15
![Мартышкины]() 7:09
7:09
![Сборники «Ну, погоди!»]() 1:10:01
1:10:01
![Енотки]() 7:04
7:04

 23:35
23:35Скачать видео
| 230x144 | ||
| 576x360 | ||
| 1152x720 |
 2:26
2:26
2025-10-22 14:10
 2:38
2:38
2025-10-16 11:06
 3:44
3:44
2025-10-21 09:25
 4:38
4:38
2025-10-23 11:27
 3:23
3:23
2025-10-16 10:00
 3:51
3:51
2025-10-16 10:57
 3:05
3:05
2025-10-17 11:37
 3:15
3:15
2025-10-18 10:02
 3:13
3:13
2025-10-18 09:47
 3:46
3:46
2025-10-14 11:30
 3:33
3:33
2025-10-22 13:57
 3:13
3:13
2025-10-24 12:18
 3:27
3:27
2025-10-16 11:15
 3:45
3:45
2025-10-15 10:45
 3:40
3:40
2025-10-15 11:15
 2:29
2:29
2025-10-24 11:25
 3:18
3:18
2025-10-24 12:09
 3:22
3:22
2025-10-20 14:44
 3:41
3:41
2025-10-23 13:04
 3:20
3:20
2025-10-15 10:27
0/0
 1:29:32
1:29:32
2025-09-15 11:39
 1:28:32
1:28:32
2025-10-07 09:27
 1:51:56
1:51:56
2025-09-24 11:35
 1:36:32
1:36:32
2025-08-28 15:32
 1:54:10
1:54:10
2025-08-27 17:17
 2:13:21
2:13:21
2025-09-09 12:49
 1:31:20
1:31:20
2025-08-27 17:17
 1:42:30
1:42:30
2025-10-14 20:27
 1:29:30
1:29:30
2025-09-11 08:20
 1:41:29
1:41:29
2025-08-15 19:31
 1:45:29
1:45:29
2025-10-23 18:26
 1:46:00
1:46:00
2025-08-27 17:17
 1:49:20
1:49:20
2025-10-21 22:50
 1:27:40
1:27:40
2025-08-27 17:17
 1:54:48
1:54:48
2025-10-01 15:17
 1:29:27
1:29:27
2025-09-07 22:44
 1:54:40
1:54:40
2025-09-24 11:35
 2:01:55
2:01:55
2025-08-28 15:32
 1:33:34
1:33:34
2025-10-08 12:27
 1:54:19
1:54:19
2025-08-27 18:01
0/0
 13:00
13:00
2024-11-29 13:39
 12:12
12:12
2024-11-29 14:21
 3:27
3:27
2024-12-07 11:00
 1:13
1:13
2024-11-29 14:40
 7:42
7:42
2024-12-17 12:21
2021-09-24 16:00
 11:04
11:04
2023-05-18 16:41
 7:09
7:09
2023-07-06 19:20
2021-09-22 21:29
 45:30
45:30
2025-09-17 18:49
 13:06
13:06
2024-11-28 16:30
 21:08
21:08
2025-01-09 16:39
 6:30
6:30
2022-03-31 13:09
 11:20
11:20
2025-09-12 10:05
 12:24
12:24
2024-11-27 13:24
 1:04:60
1:04:60
2025-09-02 13:47
 1:05:15
1:05:15
2025-09-30 13:45
 7:09
7:09
2025-04-01 16:06
 1:10:01
1:10:01
2025-07-25 20:16
 7:04
7:04
2022-03-29 18:22
0/0